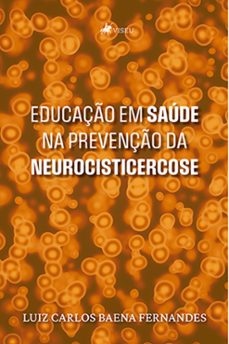
educaço em saude na prevenço da neurocisticercose (ebook)-luiz carlos baena fernandes-9786525471402

Ebooks de medicina, página 15 de 361
Categorias
Filtros
GUERIS, SELMA
Viseu 9786525493206
eBook
MD, PAULO H. KLEIN.
Viseu 9786525491769
eBook
BORGES, LUCAS LOURENÇO
Viseu 9786525493503
eBook
RAMALHO, ANDRÉ
Viseu 9786525489575
eBook
SOBRINHO, STELLA
Viseu 9786525488059
eBook
PAULO_AEIOU
Viseu 9786525488233
eBook
SOCORRO, MARIA
Viseu 9786525487731
eBook
SATO, VANESSA
Viseu 9786525487779
eBook
BREGALDA, GIANCARLO GEHLEN
Viseu 9786525488196
eBook
TRINDADE, ELANE y LIMA, SINTIQUE DA SILVA
Viseu 9786525485133
eBook
NEVES, JOSÉ
Viseu 9786525479910
eBook
DARIO, PAULO HENRIQUE P. y REINISCH, NICOLE
Viseu 9786525485157
eBook
DIAS, MARCOS VIVIANO
Viseu 9786525483511
eBook
SAKAVICIUS, CAMILA
Viseu 9786525477060
eBook
FILHO, VENÂNCIO DANTAS
Viseu 9786525472980
eBook
FERNANDES, LUIZ CARLOS BAENA
Viseu 9786525471402
eBook
CATTANI, GUILHERME
Editora Novo Século 9786555617450
eBook
JOTA, DR.
Viseu 9786525466118
eBook
U.S. DEPARTMENT OF DEFENSE
Good Press 8596547811800
eBook
DEPARTMENT OF THE ARMY, DEPARTMENT OF THE NAVY y DEPARTMENT OF THE AIR FORCE
Good Press 8596547793489
eBook